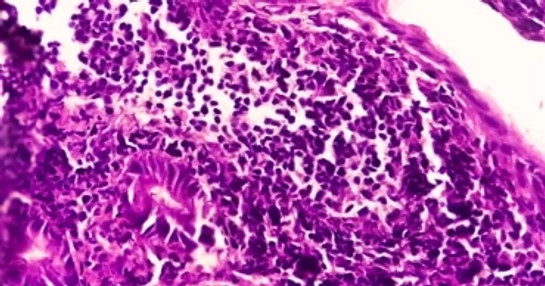
Immuno-Oncology-non-small-cell-lung-cancer

Infectious Diseases
COVID-19 has raised the importance of research into fighting infectious diseases that threaten populations.

COVID-19 vaccines: Post-authorisation safety surveillance
This whitepaper explores the multifaceted challenges of COVID-19 post-authorisation safety surveillance studies and how business intelligence tools can benefit these efforts.

Assessing strategies for mitigating infectious diseases
Public health officials turn to evidence as the basis for their health policies to control the spread of infections. However, many nuanced factors can influence variations in the number of infections caused by a single infected individual.
Watch the webinar: An introduction to infectious disease modelling
In this whitepaper, we explain the basic measures used to quantify infectious disease transmission and introduce the principles of dynamic modelling to inform the selection of the most effective and cost-efficient strategies for mitigating infectious diseases.
Fortifying vaccines: Preparation and prevention against future infectious disease epidemics
This whitepaper presents infrastructural and strategic considerations for strengthening vaccine development so that the medical community will be prepared to respond to future pandemics and novel diseases.
Antimicrobial resistance
The World Health Organization calls antimicrobial resistance, resulting from the overuse of antibiotics or other drugs, one of the top 10 public health threats. In fact, the next global pandemic could be another novel respiratory pathogen of zoonotic origins or a multidrug resistant strain of a previously eradicated pathogen.
In this whitepaper we provide a framework for understanding the antimicrobial crisis and the role healthcare and biopharma industries have to play in mitigating the impact of future pandemics.
The evolution of HIV treatments
HIV is highly heterogeneous, creating barriers to diagnosing and treating the disease. Moreover, the HIV epidemic varies by region and country, necessitating different clinical research strategies across geographies. In this whitepaper, we discuss opportunities for addressing these challenges, best practices for managing infectious disease clinical trials and recent developments in HIV treatment.
Pandemic respiratory vaccine clinical trials: A departure from business as usual
Vaccine trials for respiratory viruses, even in the best of circumstances, present a number of operational challenges for researchers, many of which are exacerbated in the face of a pandemic created by a novel virus. We focus on the corresponding success factors that can keep pandemic respiratory vaccine trials running at optimal speed and efficiency.
HIV infographic
HIV treatments: What has been achieved?
Before antiretroviral treatment availability, life expectancy for a person living with HIV was reduced by approximately 12.5 years. Now, this same individual will have near-normal life expectancy.
Infectious diseases and vaccines blogs

The race to develop combination vaccines – and the importance of indirect effects
A development race is currently underway in the field of combination vaccines, with a number of influential pharmaceutical and biotech companies pursuing combination vaccines targeting influenza and COVID-19.

Disease surveillance in low- and middle-income countries
Disease surveillance and reporting is critical to public health, enabling faster and better response to infectious disease outbreaks.

Disease surveillance and innovative vaccines
Learn about current approaches to disease surveillance and why they are important for the advancement of vaccine development in this blog.

Pre-emptive vaccine research to improve EID response
This blog explores strategies for strengthening vaccine development so that the medical community is better prepared to respond to future epidemics.

From clinician visits to data analysis: the challenges and solutions in COVID vaccine pharmacovigilance
Learn more about the challenges and solutions in assessing the long-term effects of Covid and Covid vaccines in this blog.

Combatting AMR with new tools to diagnose and treat infectious disease
The employment of antimicrobials to fight previously devastating microbial diseases, such as tuberculosis, meningitis and pneumonia has been a transformative medical achievement.

ICON Joins UNICEF Corporate Vaccine Alliance
ICON is one of seven leading Irish companies that just endorsed an open letter urging fellow corporate leaders to join the UNICEF Corporate Vaccine Alliance.

Battling HIV on many fronts
Discover how in-home services and a global development strategy can help us get closer to more effective treatments.

mRNA vaccines from COVID-19 to HIV
How one virus accelerated vaccine research, spurring innovation and hope for a cure in another

C diff and COVID-19, is this a health risk that can be dealt with sooner than later?
Today, with the development, widespread use, and poor prescribing practices of antibiotics over time, C diff infection rates have increased exponentially.

Post pandemic clinical trial strategies: How COVID-19 altered clinical trials forever and what’s next
How COVID-19 altered clinical trials forever and what’s next?

Diagnostics on the frontlines of COVID-19
As the COVID-19 crisis continues to unfold, there is an immediate need for rapid diagnostic testing to identify and track people infected by or exposed to coronavirus.
Infectious diseases and vaccines media contributions
-

Media article: Overcoming challenges with maternal vaccine trials
Тhis article outlines the challenges with maternal vaccine trials and how with careful planning and execution, these can be overcome throughout the trial process.
-
Media article: From Vaccines to Oncology and Beyond: Tracking mRNA’s Progress
In this article, ICON’s Andreas Dreps and Martin Lachs discuss how the success of mRNA-based vaccines paves the way for mRNA in oncology and beyond.
-

Media article: Decoding pandemic precision: From SARS-CoV-2 to influenza vaccination strategies
In this article in Open Access Government, ICON's epidemiologist Dr. Richard Pitman discusses vaccination strategies and what needs to change.
-

Media article: Logistical considerations in mRNA vaccine development
In this article, ICON’s Andreas Dreps and Martin Lachs discuss the logistical considerations in mRNA vaccine development.
-

Media article: ICON partners with US Government for clinical trials of Covid-19 vaccines
The article on Clinical Trials Arena reports that ICON will conduct a phase 2b clinical trial for the US BARDA-selected Covid-19 vaccine candidate as part of Project NextGen.
-

Media article: BARDA, ICON partner to execute next-gen COVID vaccine trial
This news article from Contract Pharma reports that ICON will execute a Phase 2b clinical trial to assess the relative efficacy of a next generation COVID-19 vaccine.
-

Media article: ICON in pact with BARDA for next-gen COVID vaccine trial
The piece from Seeking Alpha highlights that the trial is designed to evaluate the vaccine candidate selected by BARDA, which functions as part of the Administration for Strategic Preparedness and Response under the U.S. Department of Health and Human Services.
-

Media article: ICON to partner with US government agency to test COVID vaccine candidates
This news article from Reuters outlines that, as part of the collaboration with Biomedical Advanced Research and Development Authority, ICON will conduct a mid-stage trial of 10,000 participants to assess the efficacy of a next generation COVID-19 vaccine relative to currently available shots.
Receive more insights on infectious diseases and vaccines from ICON
Please visit ICON's Preference Centre and select 'Infectious Diseases and Vaccines' under 'Therapeutic Areas of Interest' to receive new insights on infectious diseases and vaccines.
Infectious diseases and vaccines services
ICON’s extensive Infectious Disease expertise enables us to consistently select the best sites, expedite start-up timelines, and achieve enrolment targets for our clients. We apply proven strategies to clinical trials that minimise risk and generate high-quality, reliable data reducing the time and cost of bringing new therapies to market.




